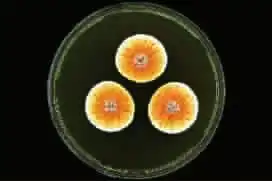
新疆活化石仙女虾霸气侧漏盘点你绝对没见过的稀有物种
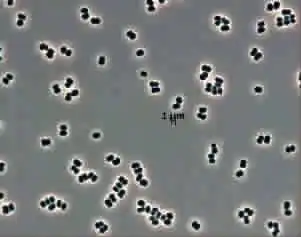
新疆活化石仙女虾霸气侧漏盘点你绝对没见过的稀有物种

霸气侧漏女头像朝鲜

女星下腰柳岩霸气侧漏,小彩旗惊为天人而这位为此苦不堪言

孙俪刘诗诗杨幂佟丽娅唐嫣小花旦容貌演技综合pk

此城彼人雍莉等外国人镜头下的西安变迁

高颜值中国明星组团亮相时尚奥斯卡女星红毯竞艳

明星遭遇年龄测试吴亦凡范冰冰赵薇陈坤20多周迅才19

尚雯婕网游主题曲画出我世界mv海量花絮曝光

海瑟薇朱莉女星胸型好不好乳房侧漏知分晓

女星征战metgala巩俐雍容范冰冰华丽汤唯脱俗

露乳露胸贴女星性感礼服侧露胸部危险大

谢娜晒逛街照被指霸气侧漏网友在等杰哥吗

安妮公主玩性感v领礼服侧露性感无限
新疆活化石仙女虾霸气侧漏盘点你绝对没见过的稀有物种

新疆活化石仙女虾霸气侧漏盘点你绝对没见过的稀有物种

千颂伊范玮琪刘嘉玲孙俪杨幂女明星购豪宅花千万眼睛都不眨

fashion不难,难的是让自己fashion到老
新疆活化石仙女虾霸气侧漏盘点你绝对没见过的稀有物种